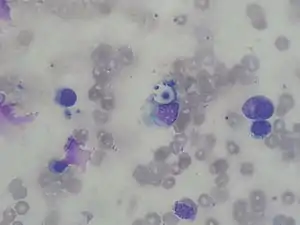

Cryptococcosis
| Cryptococcosis | |
|---|---|
Other names: Busse-Buschke disease, cryptococcic meningitis, cryptococcosis lung, cryptococcosis skin, European Blastomycosis, torular meningitis, torulosis[1]
![]() ![]() text: From left to right: Cryptococcosis lung, cryptococcosis brain | |
| Pronunciation | |
| Specialty | Infectious disease[4] |
| Symptoms |
|
| Causes | Cryptococcus neoformans,[7] Cryptococcus gattii[8] |
| Risk factors | HIV/AIDS[9] |
| Diagnostic method | Biopsy, culture[9] |
| Treatment | Antifungal medication[10] |
| Medication | |
Cryptococcosis is a potentially fatal fungal infection of mainly the brain, where it appears as a meningitis, and the lungs, presenting as a pneumonia.[4][9] Cough, difficulty breathing, chest pain and fever are seen when the lungs are infected.[5] When the brain is infected, symptoms include headache, fever, neck pain, nausea and vomiting, light sensitivity and confusion or changes in behaviour.[5] It can also affect other parts of the body including skin, where it may appear as several fluid-filled nodules with dead tissue.[6]
It is caused by the fungi Cryptococcus neoformans or less commonly Cryptococcus gattii, and is acquired by breathing in the spores from the air.[4] These fungi are found around the world in soil, decaying wood, pigeon droppings, and in the hollows of some species of trees.[9][12] Whereas C. neoformans infects generally people with HIV/AIDS and those on immunosuppressant drugs and does not usually affect fit and healthy people, C. gattii (found in some parts of Canada and the US) does.[9][12] Once breathed in, the dried yeast cells colonize the lungs, where they are either cleared by immune cells, lie dormant, or cause infection and spread.[13]
Diagnosis is by isolating Cryptococcus from a sample of affected tissue or direct observation of the fungus by using India ink staining of body fluids.[9] It can be cultured from a cerebrospinal fluid, sputum, and skin biopsy.[9] Treatment is with fluconazole or amphotericin B.[9][11]
Data from 2009 estimated that of the almost one million cases of cryptococcal meningitis that occurred worldwide annually, 700,000 occurred in sub-Saharan Africa and 600,000 per year died.[14] Cryptococcosis was rare before the 1970s which saw an increase in at-risk groups such as people with organ transplant or on immunosuppressant medications.[9] The number of cases escalated in the mid-1980s with over 80% occurring in people with HIV/AIDS.[9]
Classification
Cryptococcus is generally classified according to how it is acquired. It typically begins in the lungs before spreading to other parts of the body, particularly the brain and nervous system.[1] The skin type is less common.[1]
Signs and symptoms
Cough, shortness of breath, chest pain and fever are seen when the lungs are infected, appearing like a pneumonia.[5] There may also be feeling of tiredness.[4] When the brain is infected, symptoms include headache, fever, neck pain, nausea and vomiting, light sensitivity, confusion or changes in behaviour.[5] It can also affect other parts of the body including skin, eyes, bones and prostate.[9] In the skin, it may appear as several fluid-filled nodules with dead tissue.[6] Depending on the site of infection, other features may include loss of vision, blurred vision, unable to move an eye and memory loss.[9]
Symptom onset is often sudden when lungs are infected and gradual over several weeks when the central nervous system is affected.[9]
Lung
Cryptococcus (both C. neoformans and C. gattii) plays a common role in pulmonary invasive mycosis seen in adults with HIV and other immunocompromised conditions.[15] It also affects healthy adults at a much lower frequency and severity as healthy hosts may have no or mild symptoms.[16] Immune-competent hosts may not seek or require treatment, but careful observation may be important.[17] Cryptococcal pneumonia has a potential to disseminate to the central nervous system (CNS) especially in immunocompromised individuals.[18]
Pulmonary cryptococcosis has a worldwide distribution and is commonly underdiagnosed due to limitations in diagnostic capabilities. Since pulmonary nodules are its most common radiological feature, it can clinically and radiologically mimic lung cancer, TB, and other pulmonary mycoses. The sensitivity of cultures and the Cryptococcal (CrAg) antigen with lateral flow device on serum are rarely positive in the absence of disseminated disease.[15] Moreover, pulmonary cryptococcosis worsen the prognosis of cryptococcal meningitis.[15]
Brain
Cryptococcal meningitis (infection of the meninges, the tissue covering the brain) is believed to result from dissemination of the fungus from either an observed or unappreciated pulmonary infection. Often there is also silent dissemination throughout the brain when meningitis is present. Cryptococcus gattii causes infections in immunocompetent people (fully functioning immune system), but C. neoformans v. grubii, and v. neoformans usually only cause clinically evident infections in persons with some form of defect in their immune systems (immunocompromised persons). People with defects in their cell-mediated immunity, for example, people with AIDS, are especially susceptible to disseminated cryptococcosis. Cryptococcosis is often fatal, even if treated.[19]
Though the rate of infection is clearly higher with immunocompromised individuals, some studies suggest a higher mortality rate in patients with non-HIV cryptococcal meningitis secondary to the role of T-cell mediated reaction and injury.[20] CD4+ T cells have proven roles in the defense against Cryptococcus, but it can also contribute to clinical deterioration due its inflammatory response.[21]
Skin
Primary Cutaneous Cryptococcosis (PCC) is a distinct clinical diagnosis separate from the secondary cutaneous cryptococcosis that is spread from systematic infection. Males are more likely to develop the infection and a 2020 study showed that the sex bias may be due to a growth hormone, produced by C. neoformans called gibberellic acid (GA) that is upregulated by testosterone.[22] The upper limbs account for a majority of infections. Isolates found in PCC include Cryptococcus neoformans (most common), Cryptococcus gattii, and Cryptococcus laurentii. Prognosis for PCC is generally good outside of disseminated infection.[23]
Morphologic description of the lesions show umbilicated papules, nodules, and violaceous plaques that can mimic other cutaneous diseases like molluscum contagiosum and Kaposi's sarcoma. These lesions may be present months before other signs of system infection in patients with AIDS.[24]
Cause
It is caused by the fungi Cryptococcus neoformans or less commonly Cryptococcus gattii, and is acquired by breathing in the spores from the air.[4] These fungi are found around the world in soil, decaying wood, pigeon droppings, bat excreta, ameba and sowbugs, and in the hollows of some species of trees.[9][6][12] Whereas C. gattii also lives in mainland British Columbia, Vancouver Island, Oregon, Washington and California, and affects healthy people as well those with a weak immune system, C. neoformans rarely affects healthy people, and is the predominate cause of infection in the brain in people with HIV/AIDS in sub-Saharan Africa.[8]
Although the most common presentation of cryptococcosis is of C. neoformans infection in an immunocompromised person (such as persons living with AIDS), the C. gattii is being increasingly recognized as a pathogen in what is presumed to be immunocompetent hosts,[25] especially in Canada and Australia. This may be due to rare exposure and high pathogenicity, or to unrecognized isolated defects in immunity, specific for this organism.
Risk factors
People most at risk include those with HIV/AIDS, people taking high doses of steroids, and those on cancer chemotherapy or who have had an organ transplantation.[26]
Other conditions that pose an increased risk include certain lymphomas (e.g., Hodgkin's lymphoma), sarcoidosis, liver cirrhosis, and patients on long-term corticosteroid therapy.
Mechanism
Once breathed in, the dried yeast cells colonize the lungs, where they may be cleared by immune cells in the lung, stay latent, cause lung infection and/or spread to other parts of the body, often the brain (cryptococcal meningoencephalitis).[13]
Diagnosis
Any person who is found to have cryptococcosis at a site outside of the central nervous system (e.g., pulmonary cryptococcosis), a lumbar puncture is indicated to evaluate the cerebrospinal fluid (CSF) for evidence of cryptococcal meningitis, even if they do not have signs or symptoms of CNS disease. Detection of cryptococcal antigen (capsular material) by culture of CSF, sputum and urine provides definitive diagnosis.[27] Blood cultures may be positive in heavy infections. India ink of the CSF is a traditional microscopic method of diagnosis,[28] although the sensitivity is poor in early infection, and may miss 15–20% of patients with culture-positive cryptococcal meningitis.[29] Unusual morphological forms are rarely seen.[30] Cryptococcal antigen from cerebrospinal fluid is the best test for diagnosis of cryptococcal meningitis in terms of sensitivity.[31] Apart from conventional methods of detection like direct microscopy and culture, rapid diagnostic methods to detect cryptococcal antigen by latex agglutination test, lateral flow immunochromatographic assay (LFA), or enzyme immunoassay (EIA). A new cryptococcal antigen LFA was FDA approved in July 2011.[29][32] Polymerase chain reaction (PCR) has been used on tissue specimens.
CT scan lungs: mass in right upper lobe
MRI brain: cryptococcus
FDG PET/CT - Multiple nodules (some cavitating) in the left lower lobe
Biopsy
A special stain may be needed to see the cryptococcus capsule.[33]
Mucicarmine stain: bright pink cryptococcosis capsule[33]
Field stain: thick cryptococcosis capsule
H&E stain: histiocytic penumonia_Alcian_blue-PAS.jpg.webp)

Differential diagnosis
Cryptococcosis in the lung can appear similar to tuberculosis (TB), lung cancer, bacterial pneumonia, and other fungal infections of the lung.[15]
Prevention
Cryptococcosis is a very subacute infection with a prolonged subclinical phase lasting weeks to months in persons with HIV/AIDS before the onset of symptomatic meningitis. In Sub-Saharan Africa, the prevalence rates of detectable cryptococcal antigen in peripheral blood is often 4–12% in persons with CD4 counts lower than 100 cells/mcL.[34][35] Cryptococcal antigen screen and preemptive treatment with fluconazole is cost saving to the healthcare system by avoiding cryptococcal meningitis.[36] The World Health Organization recommends cryptococcal antigen screening in HIV-infected persons entering care with CD4<100 cells/μL.[37] This undetected subclinical cryptococcal (if not preemptively treated with anti-fungal therapy) will often go on to develop cryptococcal meningitis, despite receiving HIV therapy.[35][38] Cryptococcosis accounts for 20-25% of the mortality after initiating HIV therapy in Africa. What is effective preemptive treatment is unknown, with the current recommendations on dose and duration based on expert opinion. Screening in the United States is controversial, with official guidelines not recommending screening, despite cost-effectiveness and a 3% U.S. cryptococcal antigen prevalence in CD4<100 cells/μL.[39][40]
Antifungal prophylaxis such as fluconazole and itraconazole reduces the risk of contracting cryptococcosis in those with low CD4 cell count and high risk of developing such disease in a setting of cryptococcal antigen screening tests are not available.[41]
Treatment
Treatment options in persons without HIV-infection have not been well studied. Intravenous Amphotericin B combined with flucytosine by mouth is recommended for initial treatment (induction therapy).[42]
People living with AIDS often have a greater burden of disease and higher mortality (30–70% at 10-weeks), but recommended therapy is with amphotericin B and flucytosine. Where flucytosine is not available (many low and middle income countries), fluconazole should be used with amphotericin.[37] Amphotericin-based induction therapy has much greater microbiologic activity than fluconazole monotherapy with 30% better survival at 10-weeks.[27][43] Based on a systematic review of existing data, the most cost-effective induction treatment in resource-limited settings appears to be one week of amphotericin B coupled with high-dose fluconazole.[43] After initial induction treatment as above, typical consolidation therapy is with oral fluconazole for at least 8 weeks used with secondary prophylaxis with fluconazole thereafter.[37]
The decision on when to start treatment for HIV appears to be very different than other opportunistic infections. A large multi-site trial supports deferring ART for 4–6 weeks was overall preferable with 15% better 1-year survival than earlier ART initiation at 1–2 weeks after diagnosis.[44] A 2018 Cochrane review also supports the delayed starting of treatment until cryptococcosis starts improving with antifungal treatment.[45]
IRIS in those with normal immune function
The immune reconstitution inflammatory syndrome (IRIS) has been described in those with normal immune function with meningitis caused by C. gattii and C. grubii. Several weeks or even months into appropriate treatment, there can be deterioration with worsening meningitis symptoms and progression or development of new neurological symptoms. IRIS is however much more common in those with poor immune function (≈25% vs. ≈8%).Magnetic resonance imaging shows increase in the size of brain lesions, and CSF abnormalities (white cell count, protein, glucose) increase. Radiographic appearance of cryptococcal IRIS brain lesions can mimic that of toxoplasmosis with ring enhancing lesions on head computed tomography (CT). CSF culture is sterile, and there is no increase in CSF cryptococcal antigen titre.
The increasing inflammation can cause brain injury or be fatal.[46][47][48]
The mechanism behind IRIS in cryptococcal meningitis is primarily immunologic. With reversal of immunosuppression, there is paradoxical increased inflammation as the recovering immune system recognises the fungus. In severe IRIS cases, treatment with systemic corticosteroids has been utilized – although evidence-based data are lacking.
Epidemiology
Cryptococcosis is not notifiable in all US states.[49] Since the discovery of antiretroviral therapy, the numbers of fungal infections in people with advanced HIV/AIDS have reduced in the US and other developed countries.[49] It is a leading cause of meningitis in people with HIV/AIDS in sub-Saharan Africa.[49] Data from 2009 estimated that of the almost one million cases of cryptococcal meningitis that occurred worldwide annually, 700,000 occurred in sub-Saharan Africa and 600,000 per year died.[14] In 2009 it was estimated that the three-month case-fatality rate is 9% in high-income regions, 55% in low/middle-income regions, and 70% in sub-Saharan Africa.[19]
Pigeon breeders (or fanciers) are known to have a high incidence of cryptococcal infections including PCC due to Cryptococcus' association with pigeon droppings.[50][51]
Cryptococcus (both C. neoformans and C. gattii) is the dominant and leading[52] etiologic agent of meningitis in adults with HIV and is considered an "emerging" disease in healthy adults.[53]
Other animals
Cryptococcosis is also seen in cats and occasionally dogs. It is the most common deep fungal disease in cats, usually leading to chronic infection of the nose and sinuses, and skin ulcers. Cats may develop a bump over the bridge of the nose from local tissue inflammation. It can be associated with FeLV infection in cats. Cryptococcosis is most common in dogs and cats but cattle, sheep, goats, horses, wild animals, and birds can also be infected. Soil, fowl manure, and pigeon droppings are among the sources of infection.[54][55]
See also
References
- 1 2 3 "Cryptococcosis". NORD (National Organization for Rare Disorders). Archived from the original on 5 June 2021. Retrieved 5 June 2021.
- ↑ "Cryptococcosis". Oxford Dictionaries UK Dictionary. Oxford University Press. Retrieved 2016-01-21.
- ↑ "Cryptococcosis". Merriam-Webster Dictionary. Retrieved 2016-01-21.
- 1 2 3 4 5 "ICD-11 - ICD-11 for Mortality and Morbidity Statistics". icd.who.int. Archived from the original on 1 August 2018. Retrieved 5 June 2021.
- 1 2 3 4 5 6 "Symptoms of C. neoformans Infection | Fungal Diseases | CDC". www.cdc.gov. 14 January 2021. Archived from the original on 27 June 2021. Retrieved 5 June 2021.
- 1 2 3 4 Johnstone, Ronald B. (2017). "25. Mycoses and Algal infections". Weedon's Skin Pathology Essentials (2nd ed.). Elsevier. p. 446. ISBN 978-0-7020-6830-0. Archived from the original on 2023-06-30. Retrieved 2023-06-16.
- ↑ "C. neoformans Infection | Fungal Diseases | CDC". www.cdc.gov. 29 December 2020. Archived from the original on 27 June 2021. Retrieved 5 June 2021.
- 1 2 "Where C. gattii Infection Comes From | Fungal Disease | CDC". www.cdc.gov. 29 January 2021. Archived from the original on 28 June 2021. Retrieved 5 June 2021.
- 1 2 3 4 5 6 7 8 9 10 11 12 13 14 15 Maziarz, Eileen K.; Perfect, John R. (2016). "Cryptococcosis". Infectious disease clinics of North America. 30 (1): 179–206. doi:10.1016/j.idc.2015.10.006. ISSN 0891-5520. PMID 26897067. Archived from the original on 2020-08-13. Retrieved 2021-06-05.
- ↑ Barlow, Gavin; Irving, Irving; moss, Peter J. (2020). "20. Infectious diseases". In Feather, Adam; Randall, David; Waterhouse, Mona (eds.). Kumar and Clark's Clinical Medicine (10th ed.). Elsevier. p. 560. ISBN 978-0-7020-7870-5. Archived from the original on 2021-08-28. Retrieved 2021-06-13.
- 1 2 "Treatment for C. neoformans Infection | Fungal Diseases | CDC". www.cdc.gov. 14 January 2021. Archived from the original on 27 June 2021. Retrieved 6 June 2021.
- 1 2 3 "Where C. neoformans Infection Comes From | Fungal Diseases | CDC". www.cdc.gov. 2 February 2021. Archived from the original on 28 May 2021. Retrieved 5 June 2021.
- 1 2 Sabiiti, Wilber; May, Robin C. (November 2012). "Mechanisms of infection by the human fungal pathogen Cryptococcus neoformans". Future Microbiology. 7 (11): 1297–1313. doi:10.2217/fmb.12.102. ISSN 1746-0921. PMID 23075448. Archived from the original on 2021-06-08. Retrieved 2021-06-05.
- 1 2 Vallabhaneni, Snigdha; Mody, Rajal K.; Walker, Tiffany; Chiller, Tom (2016). "1. The global burden of fungal disease". In Sobel, Jack; Ostrosky-Zeichner, Luis (eds.). Fungal Infections, An Issue of Infectious Disease Clinics of North America. Philadelphia: Elsevier. pp. 3–4. ISBN 978-0-323-41649-8. Archived from the original on 2021-06-05. Retrieved 2021-06-05.
- 1 2 3 4 Setianingrum, Findra; Rautemaa-Richardson, Riina; Denning, David W. (1 February 2019). "Pulmonary cryptococcosis: A review of pathobiology and clinical aspects". Medical Mycology. 57 (2): 133–150. doi:10.1093/mmy/myy086. ISSN 1460-2709. PMID 30329097. Archived from the original on 28 August 2021. Retrieved 6 June 2021.
- ↑ Choi KH, Park SJ, Min KH, Kim SR, Lee MH, Chung CR, Han HJ, Lee YC. Treatment of asymptomatic pulmonary cryptococcosis in immunocompetent hosts with oral fluconazole. Scand J Infect Dis. 2011 May;43(5):380-5. doi: 10.3109/00365548.2011.552521. Epub 2011 Jan 28. PMID: 21271944.
- ↑ Saag MS, Graybill RJ, Larsen RA, Pappas PG, Perfect JR, Powderly WG, Sobel JD, Dismukes WE. Practice guidelines for the management of cryptococcal disease. Infectious Diseases Society of America. Clin Infect Dis. 2000 Apr;30(4):710-8. doi: 10.1086/313757. Epub 2000 Apr 20. PMID: 10770733.
- ↑ Brizendine KD, Baddley JW, Pappas PG. Pulmonary cryptococcosis. Semin Respir Crit Care Med. 2011 Dec;32(6):727-34. doi: 10.1055/s-0031-1295720. Epub 2011 Dec 13. PMID: 22167400.
- 1 2 Park BJ, Wannemuehler KA, Marston BJ, Govender N, Pappas PG, Chiller TM (20 February 2009). "Estimation of the current global burden of cryptococcal meningitis among persons living with HIV/AIDS". AIDS. 23 (4): 525–30. doi:10.1097/QAD.0b013e328322ffac. PMID 19182676. S2CID 5735550.
- ↑ Anjum, Seher; Williamson, Peter R. (September 2019). "Clinical Aspects of Immune Damage in Cryptococcosis". Current Fungal Infection Reports. 13 (3): 99–108. doi:10.1007/s12281-019-00345-7. ISSN 1936-3761. PMID 33101578. Archived from the original on 2021-08-28. Retrieved 2021-06-07.
- ↑ Neal LM, Xing E, Xu J, Kolbe JL, Osterholzer JJ, Segal BM, Williamson PR, Olszewski MA. CD4+ T Cells Orchestrate Lethal Immune Pathology despite Fungal Clearance during Cryptococcus neoformans Meningoencephalitis. mBio. 2017 Nov 21;8(6):e01415-17. doi: 10.1128/mBio.01415-17. PMID: 29162707; PMCID: PMC5698549.
- ↑ Tucker JS, Guess TE, McClelland EE. The Role of Testosterone and Gibberellic Acid in the Melanization of Cryptococcus neoformans. Front Microbiol. 2020 Aug 13;11:1921. doi: 10.3389/fmicb.2020.01921. PMID: 32922377; PMCID: PMC7456850.
- ↑ Du L, Yang Y, Gu J, Chen J, Liao W, Zhu Y. Systemic Review of Published Reports on Primary Cutaneous Cryptococcosis in Immunocompetent Patients. Mycopathologia. 2015 Aug;180(1-2):19-25. doi: 10.1007/s11046-015-9880-7. Epub 2015 Mar 4. PMID: 25736173.
- ↑ Murakawa GJ, Kerschmann R, Berger T. Cutaneous Cryptococcus infection and AIDS. Report of 12 cases and review of the literature. Arch Dermatol. 1996 May;132(5):545-8. PMID: 8624151.
- ↑ Tripathi K, Mor V, Bairwa NK, Del Poeta M, Mohanty BK (2012). "Hydroxyurea treatment inhibits proliferation of Cryptococcus neoformans in mice". Front Microbiol. 3: 187. doi:10.3389/fmicb.2012.00187. PMC 3390589. PMID 22783238.
- ↑ "Cryptococcosis | DermNet NZ". dermnetnz.org. Archived from the original on 4 March 2021. Retrieved 6 June 2021.
- 1 2 Rhein, J; Boulware DR (2012). "Prognosis and management of cryptococcal meningitis in patients with HIV infection". Neurobehavioral HIV Medicine. 4: 45. doi:10.2147/NBHIV.S24748.
- ↑ Zerpa, R; Huicho, L; Guillén, A (September 1996). "Modified India ink preparation for Cryptococcus neoformans in cerebrospinal fluid specimens". Journal of Clinical Microbiology. 34 (9): 2290–1. doi:10.1128/JCM.34.9.2290-2291.1996. PMC 229234. PMID 8862601.
- 1 2 Boulware, DR; Rolfes, MA; Rajasingham, R; von Hohenberg, M; Qin, Z; Taseera, K; Schutz, C; Kwizera, R; Butler, EK; Meintjes, G; Muzoora, C; Bischof, JC; Meya, DB (Jan 2014). "Multisite validation of cryptococcal antigen lateral flow assay and quantification by laser thermal contrast". Emerging Infectious Diseases. 20 (1): 45–53. doi:10.3201/eid2001.130906. PMC 3884728. PMID 24378231.
- ↑ Shashikala; Kanungo, R; Srinivasan, S; Mathew, R; Kannan, M (Jul–Sep 2004). "Unusual morphological forms of Cryptococcus neoformans in cerebrospinal fluid". Indian Journal of Medical Microbiology. 22 (3): 188–90. PMID 17642731. Archived from the original on 2020-11-25. Retrieved 2021-06-05.
- ↑ Antinori, Spinello; Radice, Anna; Galimberti, Laura; Magni, Carlo; Fasan, Marco; Parravicini, Carlo (November 2005). "The role of cryptococcal antigen assay in diagnosis and monitoring of cryptococcal meningitis" (PDF). Journal of Clinical Microbiology. 43 (11): 5828–9. doi:10.1128/JCM.43.11.5828-5829.2005. PMC 1287839. PMID 16272534. Archived (PDF) from the original on 2021-08-28. Retrieved 2021-06-05.
- ↑ Jarvis JN, Percival A, Bauman S, Pelfrey J, Meintjes G, Williams GN, et al. (2011). "Evaluation of a novelpoint-of-care cryptococcal antigen test on serum, plasma, and urine frompatients with HIV-associated cryptococcal meningitis". Clin Infect Dis. 53 (10): 1019–23. doi:10.1093/cid/cir613. PMC 3193830. PMID 21940419.
- 1 2 "Cryptococcosis pathology | DermNet NZ". dermnetnz.org. Archived from the original on 7 August 2021. Retrieved 6 June 2021.
- ↑ "FIGURE 1. Prevalence of asymptomatic antigenemia with corresponding cost per life saved based on LFA cost of $2.50 per test". Archived from the original on 2015-01-13. Retrieved 2021-06-05.
- 1 2 Meya DB, Manabe YC, Castelnuovo B, Cook BA, Elbireer AM, Kambugu A, Kamya MR, Bohjanen PR, Boulware DR (August 2010). "Cost-effectiveness of serum cryptococcal antigen screening to prevent deaths among HIV-infected persons with a CD4+ cell count < or = 100 cells/microL who start HIV therapy in resource-limited settings". Clin. Infect. Dis. 51 (4): 448–55. doi:10.1086/655143. PMC 2946373. PMID 20597693.
- ↑ Rajasingham, R; Meya, DB; Boulware, DR (Apr 15, 2012). "Integrating cryptococcal antigen screening and pre-emptive treatment into routine HIV care". Journal of Acquired Immune Deficiency Syndromes. 59 (5): e85–91. doi:10.1097/QAI.0b013e31824c837e. PMC 3311156. PMID 22410867.
- 1 2 3 World Health Organization. "Rapid advice: Diagnosis, prevention and management of cryptococcal disease in HIV-infected adults, adolescents, and children". Archived from the original on 21 February 2014. Retrieved 1 August 2012.
- ↑ Jarvis, JN; Harrison, TS; Govender, N; Lawn, SD; Longley, N; Bicanic, T; Maartens, G; Venter, F; Bekker, LG; Wood, R; Meintjes, G (2011). "Routine cryptococcal antigen screening for HIV-infected patients with low CD4+ T-lymphocyte counts—time to implement in South Africa?" (PDF). South African Medical Journal. 101 (4): 232–4. doi:10.7196/samj.4752. PMID 21786721. Archived from the original on 2021-08-28. Retrieved 2021-06-05.
- ↑ Rajasingham, R; Boulware, DR (Dec 2012). "Reconsidering cryptococcal antigen screening in the U.S. among persons with CD4 <100 cells/mcL". Clinical Infectious Diseases. 55 (12): 1742–4. doi:10.1093/cid/cis725. PMC 3501329. PMID 22918997.
- ↑ McKenney J, Smith RM, Chiller TM, Detels R, French A, Margolick J, Klausner JD (July 2014). "Prevalence and correlates of cryptococcal antigen positivity among AIDS patients—United States, 1986–2012". MMWR Morb. Mortal. Wkly. Rep. 63 (27): 585–7. PMC 4584711. PMID 25006824.
- ↑ Awotiwon, Ajibola A; Johnson, Samuel; Rutherford, George W; Meintjes, Graeme; Eshun-Wilson, Ingrid (2018-08-29). Cochrane Infectious Diseases Group (ed.). "Primary antifungal prophylaxis for cryptococcal disease in HIV-positive people". Cochrane Database of Systematic Reviews. 8: CD004773. doi:10.1002/14651858.CD004773.pub3. PMC 6513489. PMID 30156270.
- ↑ "Practice Guidelines for the Management of Cryptococcal Disease". Infectious Disease Society of America. 2010. Archived from the original on 2018-07-25. Retrieved 2021-06-05.
- 1 2 Rajasingham, Radha; Rolfes, M.A.; Birkenkamp, K.E.; Meya, D.B.; Boulware, D.R. (2012). Farrar, Jeremy (ed.). "Cryptococcal Meningitis Treatment Strategies in Resource-Limited Settings: A Cost-Effectiveness Analysis". PLOS Medicine. 9 (9): e1001316. doi:10.1371/journal.pmed.1001316. PMC 3463510. PMID 23055838.
- ↑ Boulware, DR; Meya, DB; Muzoora, Conrad; Rolfes, MA; Huppler Hullsiek, K; Musubire, Abdu; Taseera, Kabanda; Nabeta, HW; Schutz, C; Williams, DA A.; Rajasingham, R; Rhein, J; Thienemann, F; Lo, MW; Nielsen, K; Bergemann, T L.; Kambugu, A; Manabe, YC; Janoff, EN; Bohjanen, PR; Meintjes, G (26 June 2014). "Timing of Antiretroviral Therapy after Diagnosis of Cryptococcal Meningitis". New England Journal of Medicine. 370 (26): 2487–2498. doi:10.1056/NEJMoa1312884. PMC 4127879. PMID 24963568.
- ↑ Eshun-Wilson, Ingrid; Okwen, Mbah P.; Richardson, Marty; Bicanic, Tihana (24 July 2018). "Early versus delayed antiretroviral treatment in HIV-positive people with cryptococcal meningitis". The Cochrane Database of Systematic Reviews. 7: CD009012. doi:10.1002/14651858.CD009012.pub3. ISSN 1469-493X. PMC 6513637. PMID 30039850.
- ↑ Lane M, McBride J, Archer J (August 2004). "Steroid responsive late deterioration in Cryptococcus neoformans variety gattii meningitis". Neurology. 63 (4): 713–4. doi:10.1212/01.WNL.0000134677.29120.62. PMID 15326249. S2CID 42308361.
- ↑ Einsiedel L, Gordon DL, Dyer JR (October 2004). "Paradoxical inflammatory reaction during treatment of Cryptococcus neoformans var. gattii meningitis in an HIV-seronegative woman". Clin. Infect. Dis. 39 (8): e78–82. doi:10.1086/424746. PMID 15486830.
- ↑ Ecevit IZ, Clancy CJ, Schmalfuss IM, Nguyen MH (May 2006). "The poor prognosis of central nervous system cryptococcosis among nonimmunosuppressed patients: a call for better disease recognition and evaluation of adjuncts to antifungal therapy". Clin. Infect. Dis. 42 (10): 1443–7. doi:10.1086/503570. PMID 16619158.
- 1 2 3 "C. neoformans Infection Statistics | Fungal Diseases | CDC". www.cdc.gov. 26 May 2020. Archived from the original on 28 June 2021. Retrieved 5 June 2021.
- ↑ Walter JE, Atchison RW. Epidemiological and immunological studies of Cryptococcus neoformans. J Bacteriol. 1966 Jul;92(1):82-7. doi: 10.1128/JB.92.1.82-87.1966. PMID: 5328755; PMCID: PMC276199.
- ↑ Beatson M, Harwood M, Reese V, Robinson-Bostom L. Primary cutaneous cryptococcosis in an elderly pigeon breeder. JAAD Case Rep. 2019 May 7;5(5):433-435. doi: 10.1016/j.jdcr.2019.03.006. PMID: 31192987; PMCID: PMC6510938.
- ↑ Traoré FA, Cissoko Y, Tounkara TM, Sako FB, Mouelle AD, Kpami DO, Traoré M, Doumbouya M. Étiologies des méningites lymphocytaires chez les personnes vivant avec le VIH suivies dans le service des maladies infectieuses de Conakry [Causes of lymphocytic meningitis in people with HIV admitted to the Infectious Disease department of Conakry]. Med Sante Trop. 2015 Jan-Mar;25(1):52-5. French. doi: 10.1684/mst.2014.0391. PMID: 25466555.
- ↑ Pasquier E, Kunda J, De Beaudrap P, Loyse A, Temfack E, Molloy SF, Harrison TS, Lortholary O. Long-term Mortality and Disability in Cryptococcal Meningitis: A Systematic Literature Review. Clin Infect Dis. 2018 Mar 19;66(7):1122-1132. doi: 10.1093/cid/cix870. PMID: 29028957.
- ↑ "Deep Fungal Infections". Archived from the original on 2010-04-13.
- ↑ Akira Takeuchi, D. V. M. (July 2014). "Feline Cryptococcosis – WSAVA 2003 Congress – VIN". Vin.com. Archived from the original on 2007-05-23. Retrieved 2021-06-05.
Further reading
- Perfect JR, et al. (2010). "Clinical practice guidelines for the management of cryptococcal disease: 2010 update by the infectious diseases society of america". Clinical Infectious Diseases. 50 (3): 291–322. doi:10.1086/649858. PMC 5826644. PMID 20047480.
- Gullo FP, et al. (2013). "Cryptococcosis: epidemiology, fungal resistance, and new alternatives for treatment". European Journal of Clinical Microbiology & Infectious Diseases. 32 (11): 1377–1391. doi:10.1007/s10096-013-1915-8. PMID 24141976. S2CID 11317427.
- Perfect JR, et al. (2005). "Cryptococcus neoformans: a sugar-coated killer with designer genes". FEMS Immunology and Medical Microbiology. 45 (11): 395–404. doi:10.1016/j.femsim.2005.06.005. PMID 16055314. (Review)
External links
- Medscape entry on cryptococcosis Archived 2021-05-01 at the Wayback Machine
| Classification | |
|---|---|
| External resources |
|

